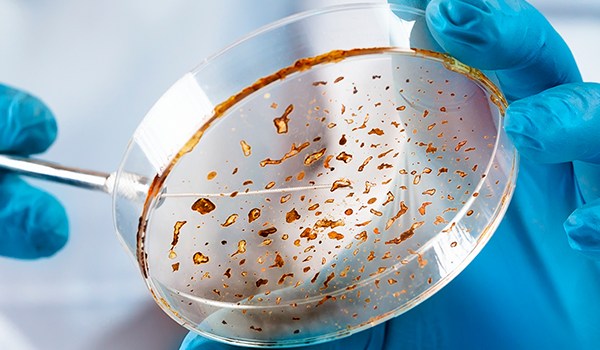
Curso Universitario en Avances en Identificación de Bacterias y Hongos en Microbiología Clínica

Curso Universitario en Avances en Identificación de Bacterias y Hongos en Microbiología Clínica
Certificación
Universidad de Vitoria-Gasteiz
El Curso Universitario en Avances en Identificación de Bacterias y Hongos en Microbiología Clínica está certificado con 50 Horas, 2 Créditos ECTS por la prestigiosa Universidad de Vitoria-Gasteiz.
La Universidad de Vitoria-Gasteiz (EUNEIZ) es una nueva universidad privada, integrada en el Sistema Universitario Vasco, que ha sido reconocida por Ley 8/2021, de 11 de noviembre (BOE – BOPV). EUNEIZ tiene por función esencial la prestación del servicio de la educación superior mediante la docencia, el estudio, la formación permanente, la investigación y la transferencia de conocimiento y de tecnología.
El compromiso de la EUNEIZ es promover el crecimiento económico y social mediante graduados y graduadas preparados para la nueva economía global desde de una formación de vanguardia apoyada en las nuevas tecnologías como elemento formativo diferencial en toda su oferta académica y en la práctica profesional como herramienta de aprendizaje.

Modelo de diploma


Plan de estudios
Requisitos de acceso
- Copia del DNI, TIE o Pasaporte por ambas caras.
Plazo inscripción
La inscripción en este curso 100% online con metodología E-Learning permanecerá abierta durante todo el año
Duración
El discente tendrá un tiempo mínimo de 1 mes para la realización de este programa formativo y un máximo de 6 meses para su finalización.
Evaluación
La evaluación estará compuesta por:
- 43 Preguntas opción múltiple (a/b/c).
Todos los alumnos deben aprobar la evaluación correspondiente a cada tema, en caso de no superar el total de las evaluaciones conjuntamente, el alumno dispone de una segunda oportunidad sin coste adicional.
Este programa formativo online con metodología E-Learning está destinado a todo aquel profesional de:
- Graduados/as en Enfermería.
- Graduados/as en Medicina.
- Técnicos/as en Cuidados Auxiliares de Enfermería.
- Técnicos/as Superiores en Laboratorio.
- Conocer los principales métodos de identificación de bacterias y hongos utilizados en microbiología clínica.
- Comprender los fundamentos teóricos y prácticos de la identificación de bacterias y hongos en muestras clínicas.
- Adquirir habilidades para realizar técnicas de identificación de bacterias y hongos de forma precisa y segura.
- Interpretar correctamente los resultados obtenidos en la identificación de bacterias y hongos y utilizarlos para el diagnóstico y tratamiento de enfermedades.
- Actualizar conocimientos sobre los avances más recientes en la identificación de bacterias y hongos en microbiología clínica.
- Desarrollar habilidades de investigación en el campo de la identificación de bacterias y hongos en microbiología clínica.
- Conocer y aplicar las normas de bioseguridad y buenas prácticas en el laboratorio de microbiología clínica.
- Fomentar el trabajo en equipo y la comunicación efectiva en el ámbito de la identificación de bacterias y hongos en microbiología clínica.
- Identificar y describir las principales características morfológicas, fisiológicas y bioquímicas de bacterias y hongos presentes en microbiología clínica.
- Aplicar técnicas de identificación de bacterias y hongos en microbiología clínica, como cultivo, tinción y pruebas bioquímicas.
- Analizar e interpretar los resultados de las técnicas de identificación microbiológica utilizadas en el laboratorio clínico.
- Evaluar la calidad de los resultados obtenidos en la identificación de bacterias y hongos en microbiología clínica, en función de los estándares y protocolos establecidos.
- Utilizar correctamente los equipos y materiales de laboratorio necesarios para la identificación de bacterias y hongos en microbiología clínica.
- Aplicar medidas de bioseguridad y control de calidad en el manejo de muestras y cultivos microbiológicos en el laboratorio clínico.
- Elaborar informes técnicos y científicos de los procedimientos y resultados obtenidos en la identificación de bacterias y hongos en microbiología clínica.
- Actualizar y ampliar los conocimientos teóricos y prácticos en el área de identificación de bacterias y hongos en microbiología clínica, a través de la revisión bibliográfica y la participación en actividades de formación continua.
- Desarrollar habilidades de trabajo en equipo y comunicación efectiva en el ámbito de la microbiología clínica.
Temario
- Introducción.
- Fundamentos de la identificación fenotípica.
- Características microscópicas.
- Características macroscópicas.
- Sistemas comerciales manuales o galerías multipruebas.
- Sistemas comerciales automatizados.
- Cultivo en medios cromogénicos.
- Resumen.
- Autoevaluación.
- Introducción.
- Genes que son diana para la identificación bacteriana.
- ARNr 16S (rrs).
- ARNr 16S-23S y ARNr 23S.
- Subunidad beta de la ARN polimerasa (rpoB).
- Subunidad beta de la ADN girasa (gyrB).
- Fundamentos de las técnicas de identificación molecular bacteriana.
- Criterios para la interpretación de resultados.
- Indicaciones de la identificación molecular.
- Identificación de bacterias de difícil cultivo.
- Desventajas de la identificación molecular.
- Algunas técnicas moleculares clásicas más de identificación.
- Nuevas técnicas de identificación molecular microbiana.
- Resumen.
- Autoevaluación.
- Introducción.
- Introducción.
- Identificación mediante MALDI-TOF: plataformas comerciales.
- Sistema VITEK MS.
- Sistema MALDI Biotyper (Bruker Daltonics) y Calibración.
- Precauciones con el microorganismo problema.
- Interpretación de resultados.
- Principales indicaciones.
- Limitaciones en la identificación de algunos microorganismos.
- Ventajas e inconvenientes de la identificación por medio de MALDI-TOF.
- Identificación por MALDI-TOF según microorganismo.
- Identificación de bacterias anaerobias.
- Identificación de levaduras.
- Identificación de hongos filamentosos y dermatofitos.
- Identificación de micobacterias.
- Identificación de Actinomycetales: Nocardia spp y Streptomyces spp.
- Identificación de parásitos: Una nueva posible aplicación.
- Otras aplicaciones de la identificación mediante MALDI-TOF.
- Resumen.
- Autoevaluación.
- Identificación de hongos filamentosos, dermatofitos y levaduras.
- Introducción.
- Identificación de hongos filamentosos y dermatofitos.
- Identificación de levaduras.
- Identificación de micobacterias.
- Identificación cromatográfica.
- Identificación mediante fagos.
- Identificación genotípica.
- Resumen.
- Autoevaluación.
- Introducción.
- PYBACT: Algoritmo para la identificación bacteriana.
- ABIS online.
- Resumen.
- Autoevaluación.
Metodología
Tu formación a distancia se adapta a ti gracias a nuestra plataforma online. Podrás acceder al contenido, descargar materiales y realizar tu formación desde cualquier lugar, sin barreras.
Empleabilidad
La orientación profesional tiene el objetivo de responder a la creciente demanda de los profesionales por adquirir las competencias y habilidades necesarias para desarrollar las actividades específicas de su ámbito laboral con las mayores garantías de éxito y calidad. Estas competencias permiten que estos profesionales se conviertan en referentes en la excelencia de los cuidados en diversas áreas.
En este sentido, nuestros programas formativos están diseñados y elaborados por profesionales de la salud con años de experiencia, por lo que están enfocados a que los alumnos adquieran esas competencias y habilidades prácticas.
¿Qué beneficios puedes obtener al realizar uno de nuestros programas formativos?
- Especialización en un ámbito o tema concreto.
- Actualización de conocimientos y puesta al día.
- Creación y ampliación de una red de contactos.
- Excelencia y referencia profesional.
- Mejora del currículum vitae.
- Posibilidades de promocionar en tu puesto laboral.






